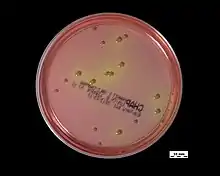

Staphylococcus epidermidis
Staphylococcus epidermidis es una especie de bacteria de la familia Staphylococcaceae[2] que forma parte de la microbiota normal de la piel y las mucosas humanas junto con otras especies de estafilococos coagulasa-negativos.[3][nota 1] Habitualmente es un organismo comensal aislado muy frecuentemente en muestras biológicas sin que tenga repercusión clínica, pero su capacidad para crear biopelículas, el principal factor de virulencia, en dispositivos como catéteres o prótesis valvulares cardíacas mecánicas hacen también a esta especie una de las causas más comunes de infección nosocomial.[4][5]
| Staphylococcus epidermidis | ||
|---|---|---|
![]() Diplococo de S. epidermidis visto con un microscopio electrónico de barrido. | ||
| Taxonomía | ||
| Dominio: | Bacteria | |
| Filo: | Bacillota | |
| Clase: | Bacilli | |
| Orden: | Bacillales | |
| Familia: | Staphylococcaceae | |
| Género: | Staphylococcus | |
| Especie: |
S. epidermidis (Winslow & Winslow 1908) Evans 1916 | |
| Sinonimia | ||
También está involucrada en otras enfermedades como la endocarditis de válvulas nativas,[6] endoftalmitis[7] y sepsis, esta última especialmente en neonatos[8] e inmunodeprimidos.[6] La mayoría de las cepas son multirresistentes a los antibióticos más usados debido sobre todo a la expresión de la proteína PBP2a que confiere resistencia a meticilina, mecanismo que comparte con algunas cepas de Staphylococcus aureus.[9] Es por esto que el tratamiento empírico de las enfermedades que provoca se realiza con la vancomicina, un fármaco del grupo de los glicopéptidos,[10] aunque existe preocupación por la existencia de cepas con una sensibilidad disminuida a este antibiótico[11] y otras que incluso son casi panresistentes.[12]
En cuanto a su microbiología, es grampositiva, anaerobia facultativa y catalasa-positiva.[13][14][15] Se puede cultivar en medios como agar sangre, donde no produce hemólisis,[15] y agar manitol salado, en el que puede diferenciarse de S. aureus porque no produce un halo amarillo como sí hace esta última.[16] La identificación de S. epidermidis en muestras biológicas puede realizarse, además del cultivo, con una baterías de pruebas bioquímicas,[5][17][18][19] PCR en tiempo real[20][21] o usando la espectrometría de masas.[22]
Etimología
Staphylococcus es una palabra de origen griego que resulta de la unión de staphylé (σταφυλή, «racimo de uvas») y kókkos (κόκκος, «grano»). Epidermidis (relativo a la epidermis) es una referencia a su abundancia en la piel humana.[23]
Historia
Esta bacteria fue descrita por primera vez en 1880 por el cirujano escocés Alexander Ogston.[4][24] Posteriormente, en 1884, el microbiólogo alemán Friedrich Julius Rosenbach la nombró como Staphylococcus albus por el color blanco de sus colonias en los medios de cultivo y en contraposición a S. aureus, que, como su nombre indica, forma colonias amarillas.[1][23] Posteriormente se cambió su nombre al actual por su presencia en la piel.[23]
Microbiología

Es una especie grampositiva y se observa al microscopio como cocos agrupados en racimos. Es inmóvil y su metabolismo es anaerobio facultativo, por lo que puede obtener energía de la respiración aerobia o la fermentación.[25] Además, la mayor parte de las cepas presentan cápsula.[26]
Respecto a sus propiedades bioquímicas, S. epidermidis es catalasa-positivo —disocia el agua oxigenada en oxígeno y agua—, coagulasa-negativo —no coagula el suero—, oxidasa-negativo y ureasa-positivo. Además, alrededor del 80 % de las cepas son nitrato reductasa-positivas y la mitad de las cepas tienen actividad termonucleasa débil. En cuanto a los glúcidos, puede fermentar la glucosa, la lactosa y la maltosa, pero no la trehalosa ni el manitol.[5][15][27] Al no poder fermentar esta última molécula, las colonias en el agar manitol salado no cambian el color del medio, que es rojo.[16][28][29][nota 2]
Crece rápidamente en los medios de cultivo[30] y forma colonias lisas de color gris o blanco grisáceo que pueden variar de opacidad y tener una apariencia mucoide o incluso ser pegajosas.[31] Además, es un organismo mesófilo,[32] por lo que puede crecer entre los 15 °C y los 45 °C y la temperatura óptima para ello es de 30-37 °C.[31] En el medio de agar sangre no produce hemólisis[15] (por lo que se clasifica como γ-hemolítico).[33] También soporta concentraciones de sal del 7,5 %,[31] capaces de inhibir el crecimiento de muchos microorganismos y similares a las del medio agar manitol salado, que es selectivo para Staphylococcus;[29][34] sin embargo, prolifera mal cuando la concentración de NaCl alcanza el 10 %.[31]
Genoma
El genoma de S. epidermidis ha sido secuenciado por completo en multitud de cepas distintas y existen más de ochocientos registros en la base de datos del NCBI.[35] El genoma representativo (cepa ATCC 12228), que no expresa muchos de los genes relacionados con la patogenicidad, comprende un cromosoma principal y seis plásmidos; tiene además una longitud algo mayor que 2,5 Mb y un contenido GC del 32,1 %.[35][36] Por otra parte, la segunda cepa cuyo genoma fue secuenciado, que sí es capaz de formar biopelículas y es resistente a la meticilina, fue la RP62A y cuenta con una longitud de 2,6 Mb y un solo plásmido.[37]
Microbiota normal
S. epidermidis es parte de la microbiota normal del ser humano. Está presente en la piel y mucosas, especialmente en lugares húmedos como axilas, periné, ingles, narinas y conjuntivas.[3][6] y se ha asociado con efectos beneficiosos (inhibición del crecimiento de microorganismos patógenos como S. aureus, S. pyogenes y, en ratones, C. albicans) y perjudiciales (se aísla en grandes cantidades en las lesiones de la dermatitis atópica).[38] Es una de las primeras bacterias que se pueden detectar en el intestino, al menos en los humanos occidentales modernos, y comienza a colonizar la piel varios días o semanas después del nacimiento. También se ha aislado en gatos, vacas, perros, cabras, caballos, cerdos, ovejas y gorilas, pero no se puede descartar que en alguno de estos casos la bacteria haya sido transmitida desde un humano y no formen realmente parte de la microbiota normal de estos animales.[6]
Factores de virulencia

El principal factor de virulencia de esta especie es la capacidad para crear biopelículas. Las cepas que poseen el operón ica y las secuencias de inserción IS256, correspondientes al perfil alélico ST2, se relacionan con esta característica.[14] Sin embargo, existen cepas patógenas sin los genes ica que también son capaces de formarlas.[14][39]
La formación de biopelículas comprende tres períodos: adhesión, acumulación y dispersión.[8] El primer paso consiste en la adherencia de las bacterias a superficies inertes, como las de catéteres o distintos tipos de implantes. Para ello, S. epidermidis puede sintetizar varios componentes que lo permiten, entre los que destaca PIA (adhesina de polisacárido intercelular), un polisacárido de N-acetilglucosamina con enlaces β(1→6).[40] También intervienen en la adhesión otras moléculas como las proteínas Bap y Aap, el ácido teicoico o ADN extracelular.[14] Cuando las bacterias forman una biopelícula, la resistencia a antibióticos aumenta. Esto se debe a que se inhiben procesos metabólicos que son dianas terapéuticas frecuentes como la replicación de ADN y la síntesis de proteínas y de pared celular. También se dificulta la penetración del antibiótico a través de la matriz extracelular.[14][38] El sistema inmunológico sufre alteraciones debido a la PIA, como el aumento del factor C5a del sistema del complemento en el plasma y la inhibición de citocinas proinflamatorias y la fagocitosis.[8]
La dispersión de cúmulos de células del biofilm está controlada por un sistema genético de percepción de cuórum llamado agr. Su baja actividad en la superficie de la biopelícula provoca la degradación de moléculas de adhesión y la disgregación controlada de bacterias.[14] Otras enzimas relacionadas con la virulencia —pero no con la formación de biopelículas— halladas en aproximadamente la mitad de las cepas patógenas de S. epidermidis son la lipasa y la lecitinasa.[5]
Enfermedad
Infecciones de dispositivos médicos
S. epidermidis es una causa común de infección relacionada con catéter intravascular, la cual es consecuencia directa de la formación de biopelículas. Se estima que el conjunto de los estafilococos coagulasa-negativos provocan entre el 30 % y 40 % de estas infecciones, debido a que su presencia en la piel permite la colonización del dispositivo durante su inserción. Son más corrientes en vías centrales que en vías periféricas por el lugar de inserción, el brazo o la mano en estas últimas, y el tiempo de uso, más corto también en las periféricas.[4] La enfermedad se manifiesta clínicamente como una bacteriemia persistente y es posible que se complique con una glomerulonefritis mediada por inmunocomplejos cuando es de larga evolución.[30]
Las prótesis valvulares cardíacas mecánicas también son susceptibles de sufrir una infección por este microorganismo y se considera que es la causa más frecuente, seguida de S. aureus.[4] Cuando ocurre, lo suele hacer en los primeros doce meses tras su colocación y tiene tendencia a cronificarse. Se produce una endocarditis cuyas complicaciones son la disfunción de la válvula, la formación de abscesos y la insuficiencia cardíaca. Además de administrar terapia antibiótica, en muchos casos debe retirarse la prótesis.[4][6][41] Otros implantes que esta bacteria infecta frecuentemente son las prótesis intraarticulares y las derivaciones de líquido cefalorraquídeo, que suelen cursar con meningitis. Técnicamente, cualquier dispositivo médico puede ser colonizado por esta especie.[6]
Otras infecciones
Los estafilococos coagulasa-negativos provocan entre el 1 % y el 5 % de endocarditis en válvulas nativas, por lo que son una causa poco común. Sin embargo, S. epidermidis es, con diferencia, el microorganismo que más veces está implicado en esta enfermedad dentro de este grupo de Staphylococcus. La proporción se eleva hasta el 15 % cuando el paciente es adicto a drogas por vía parenteral.[6]
Los neonatos prematuros con muy bajo peso (<1500 g)[42] que necesitan ventilación mecánica o uso de catéteres umbilicales o centrales tienen un mayor riesgo de sufrir una sepsis neonatal por S. epidermidis. Es una de las causas principales de sepsis de instauración tardía (más de 72 horas después del nacimiento) y se ha relacionado con otras enfermedades como displasia broncopulmonar, lesión de la sustancia blanca, enterocolitis necrotizante y retinopatía del prematuro.[8] Además de la infección de catéter, pueden sufrir abscesos, neumonía, onfalitis, meningitis, enterocolitis e infección del tracto urinario. Provoca un alargamiento del ingreso hospitalario y una mayor morbilidad; sin embargo, la mortalidad es baja.[4] Además, los estafilococos coagulasa-negativos son la causa más habitual de bacteriemia en los pacientes inmunodeprimidos, especialmente los tratados con quimioterapia. De entre todos ellos, S. epidermidis es el que se aísla con más asiduidad.[6]
En cuanto a las endoftalmitis, los estafilococos coagulasa-negativos se relacionan especialmente con las posteriores a cirugía de cataratas, las postraumáticas y las que ocurren después de una inyección intravítrea.[43] En un estudio retrospectivo en Castilla-La Mancha que analizó 63 casos durante trece años, el 36 % de las infecciones por estafilococos coagulasa-negativos tenían como causa S. epidermidis, sobre todo en las endoftalmitis postquirúrgicas. El pronóstico fue más favorable que cuando el microorganismo patógeno era S. aureus o un estreptococo.[7]
Diagnóstico

El primer paso en el diagnóstico, además de identificar los signos de infección, es la obtención de una muestra biológica. En las infecciones de vías existen métodos semicuantitativos para calcular la cantidad de microorganismos en un cultivo del catéter,[6][10] y también se pueden hacer hemocultivos en los casos de bacteriemia.[10][nota 3] Es recomendable obtener una muestra de sangre a través de la vía y otra por venopunción. Si se observa crecimiento bacteriano en menos de veinticinco horas se considera el cultivo como positivo y el vial obtenido a través del catéter debería mostrar proliferación bacteriana antes que el otro —se considera que unas dos horas de diferencia es un buen marcador— debido a que tiene un inóculo mayor.[4] Es útil realizar posteriormente la observación de una muestra al microscopio óptico con la tinción de Gram, ya que da datos sobre la morfología y la composición de la pared celular. También se recomienda hacer subcultivos en medios sólidos y un antibiograma.[45]
El subcultivo se puede realizar en el medio de agar manitol salado, que es selectivo para Staphylococcus. Staphylococcus aureus —la especie más virulenta del género— produce colonias amarillas (debido a los pigmentos que produce) rodeadas de un halo amarillo, que produce porque es capaz de fermentar el manitol, mientras que S. epidermidis no cambia el color del medio. Esto permite distinguir S. aureus de los estafilococos coagulasa-negativos.[16][29]
Algunas pruebas bioquímicas también son útiles para el diagnóstico. La prueba de la catalasa permite distinguir Staphylococcus de Streptococcus, que son catalasa-negativos,[46] y se puede usar la hibridación fluorescente in situ o la prueba de la coagulasa para distinguir S. aureus (además de otras especies del género poco importantes en la patología humana) de los estafilococos coagulasa-negativos.[17][25][34] Estos son resistentes al antibiótico bacitracina y sensibles a furazolidona, lo que permite distinguirlos de otros géneros de cocos grampositivos catalasa-positivos como Micrococcus, Rothia y Planococcus.[5] S epidermidis es sensible al antibiótico novobiocina y esto lo diferencia de especies similares resistentes a él como Staphylococcus saprophyticus.[18] Esta prueba puede agruparse con los test de la ureasa —positivo—, L-pirrolidonil-arilamidasa (PYR) —negativo—, ornitina descarboxilasa —resultado variable— y fermentación de la manosa —positivo— para obtener un diagnóstico a nivel de grupo (formado por S. epidermidis, S. capitis subsp. ureolyticus y S. caprae), que se puede complementar con las pruebas de fermentación de la trehalosa —negativa— y manitol —también negativa— para una identificación precisa a nivel de especie.[47] Un método más simple propuesto por Souza Antunes y colaboradores se basa en la sensibilidad de S. epidermidis a la deferoxamina y a la fosfomicina.[19]
Otras técnicas moleculares útiles para la identificación de este microorganismo son las de PCR en tiempo real, en la que se secuencia el gen que codifica el ARN ribosomal 16S [20] o el gen tuf,[21] o la espectrometría de masas con MALDI-TOF.[22]
Tratamiento

El tratamiento varía en función de la clase de infección. En los casos de infección de catéter se recomienda la retirada de este cuando existen signos de sepsis grave, choque séptico, flebitis séptica o la bacteriemia persiste por más de dos o tres días y se administra terapia antibiótica entre cinco y siete días. Si no se retira el catéter, esta se prolongaría hasta un intervalo de diez a catorce días en combinación con el sellado con antibióticos del dispositivo. Si tras la retirada de la vía en una infección no complicada los hemocultivos son negativos —y el enfermo no ha tomado antibióticos cuando se extraen las muestras— puede no administrarse ningún fármaco.[10][48]
El antimicrobiano de elección en el tratamiento empírico (cuando no se dispone del antibiograma del microorganismo) es la vancomicina (debido a la alta tasa de resistencias a meticilina), que puede asociarse a rifampicina o a un aminoglucósido como la gentamicina. En el caso de que se compruebe la sensibilidad a meticilina, puede cambiarse el antibiótico a una penicilina resistente a betalactamasa o a una cefalosporina.[6][10] Otros fármacos alternativos son el trimetoprim-sulfametoxazol, las estreptograminas, el linezolid y el ácido fusídico.[49] La infección de prótesis suele requerir la extirpación de esta y la administración de antibiótico durante un período de aproximadamente seis semanas, tras el cual se procedería a su reimplantación quirúgica.[4]
Resistencia a antimicrobianos
| Fármaco | Gen |
|---|---|
| Penicilinas | blaZ [6] |
| Meticilina (betalactámicos) | mecA [9] |
| Vancomicina | rpoB [12] |
| Rifampicina | rpoB [12] |
| Ácido fusídico | fusB [12] |
| Daptomicina | mprF [12] |
S. epidermidis produce betalactamasas plasmídicas codificadas por el gen blaZ que hace que sea resistente a la penicilina en más de un 90 % de las ocasiones en las que se aísla de pacientes hospitalizados.[6]
La resistencia a meticilina es un tipo de multirresistencia a antibióticos que se caracteriza por la expresión del gen mecA que codifica la proteína PBP2a, una proteína fijadora de penicilina con poca afinidad a todos los antibióticos betalactámicos,[50] excepto las cefalosporinas de quinta generación como el ceftobiprol y la ceftarolina.[6][51][52] La mayoría de las cepas de Staphylococcus epidermidis patógenos poseen esta clase de resistencia y pueden llegar a representar entre el 70 % y el 92 % de los aislamientos en los neonatos con sepsis.[9][53]
Existen también cepas de S. epidermidis con una resistencia intermedia a vancomicina, que es el antibiótico de elección.[11][54] Se han detectado otras prácticamente panresistentes en instituciones sanitarias de varios países.[12]
Profilaxis
La prevención de la infección por S. epidermidis se centra en el mantenimiento de la higiene durante los actos médicos. En la prevención de las infecciones relacionadas con catéter intravascular es importante evitar la colocación en la vena femoral debido a la alta concentración de microorganismos en la ingle. También se debe hacer un correcto lavado de manos y usar material como gorro, mascarilla y guantes y bata estériles, además de desinfectar la piel alrededor del lugar de inserción. Por otra parte, si es posible, el dispositivo debe ser colocado por personal con experiencia. Algunos catéteres impregnados en fármacos antimicrobianos activos frente a S. epidermidis o aquellos fabricados con ciertos polímeros podrían reducir la adhesión de este microorganismo a las superficies y la formación de biopelículas.[4][10]
Las prótesis neurológicas impregnadas en clindamicina y rifampicina han demostrado ser más efectivas in vitro que otras con antibióticos distintos para evitar la proliferación de estafilococos.[10] En todo caso, es necesario respetar la técnica aséptica durante la cirugía, preparar cuidadosamente al paciente y administrar una profilaxis antibiótica adecuada.[4]
Véase también
Notas
- Casi todas las especies del género Staphylococcus son coagulasa-negativas, excepto la mayoría de cepas de Staphylococcus aureus, considerada más virulenta, además de otras especies de menor relevancia.[4]
- Si pudiera fermentar el manitol, abundante en el medio, se formarían compuestos ácidos que harían virar el indicador de pH (rojo de fenol) de rojo a amarillo.[29]
- El número óptimo de extracciones de sangre seriadas es de dos a tres y cada muestra debe incubarse en dos viales, uno en aerobiosis y otro en anaerobiosis.[44]
Referencias
- «Anton Julius Friedrich Rosenbach». Who Named It? (en inglés). Consultado el 17 de enero de 2020.
- «Staphylococcus epidermidis». Taxonomy (en inglés). NCBI. Consultado el 28 de enero de 2020.
- Kloos, WE; Musselwhite, MS (1975). «Distribution and persistence of Staphylococcus and Micrococcus species and other aerobic bacteria on human skin.». Applied microbiology (en inglés) 30 (3): 381-5. PMC 187193. PMID 810086. Consultado el 18 de enero de 2020.
- Rogers, Kathie L.; Fey, Paul D.; Rupp, Mark E. (2009). «Coagulase-Negative Staphylococcal Infections». Infectious Disease Clinics of North America (en inglés) 23 (1): 73-98. PMID 19135917. doi:10.1016/j.idc.2008.10.001.
- Fariña, Norma; Carpinelli, Letizia; Samudio, Margarita; Guillén, Rosa; Laspina, Florentina; Sanabria, Ramona; Abente, Sonia; Rodas, Ladis; González, Pedro; de Kaspar, Herminia M. (2013). «Staphylococcus coagulasa-negativa clínicamente significativos. Especies más frecuentes y factores de virulencia». Revista Chilena de Infectología 30 (5): 480-488. doi:10.4067/S0716-10182013000500003. Consultado el 17 de enero de 2020.
- Becker, Karsten; Heilmann, Christine; Peters, Georg (2 de octubre de 2014). «Coagulase-Negative Staphylococci». Clinical Microbiology Reviews (en inglés) 27 (4): 870-926. PMC 4187637. PMID 25278577. doi:10.1128/CMR.00109-13. Consultado el 19 de enero de 2020.
- Asencio, María Ángeles; Huertas, María; Carranza, Rafael; Tenías, José María; Celis, Javier; González-del Valle, Fernando (2014). «Estudio microbiológico de los casos de endoftalmitis infecciosa con cultivo positivo en un periodo de 13 años». Revista Española de Quimioterapia 27 (1). ISSN 0214-3429. Consultado el 19 de enero de 2020.
- Dong, Ying; Speer, Christian P.; Glaser, Kirsten (27 de febrero de 2018). «Beyond sepsis: Staphylococcus epidermidis is an underestimated but significant contributor to neonatal morbidity». Virulence (en inglés) 9 (1): 621-633. PMC 5955464. PMID 29405832. doi:10.1080/21505594.2017.1419117. Consultado el 19 de enero de 2020.
- Katayama, Y.; Ito, T.; Hiramatsu, K. (1 de junio de 2000). «A New Class of Genetic Element, Staphylococcus Cassette Chromosome mec, Encodes Methicillin Resistance in Staphylococcus aureus». Antimicrobial Agents and Chemotherapy (en inglés) 44 (6): 1549-1555. PMC 89911. PMID 10817707. doi:10.1128/AAC.44.6.1549-1555.2000. Consultado el 25 de enero de 2020.
- von Eiff, Christof; Jansen, Bernd; Kohnen, Wolfgang; Becker, Karsten (2005). «Infections Associated with Medical Devices». Drugs (en inglés) 65 (2): 179-214. PMID 15631541. doi:10.2165/00003495-200565020-00003. Consultado el 26 de enero de 2020.
- Garrett, DO; Jochimsen, E; Murfitt, K; Hill, B; McAllister, S; Nelson, P; Spera, RV; Sall, RK; Tenover, FC; Johnston, J; Zimmer, B; Jarvis, WR (1999). «The emergence of decreased susceptibility to vancomycin in Staphylococcus epidermidis.». Infection control and hospital epidemiology (en inglés) 20 (3): 167-70. PMID 10100541. doi:10.1086/501605. Consultado el 25 de enero de 2020.
- Lee, Jean Y. H.; Monk, Ian R.; Gonçalves da Silva, Anders; Seemann, Torsten; Chua, Kyra Y. L.; Kearns, Angela; Hill, Robert; Woodford, Neil; Bartels, Mette D.; Strommenger, Birgit; Laurent, Frederic; Dodémont, Magali; Deplano, Ariane; Patel, Robin; Larsen, Anders R.; Korman, Tony M.; Stinear, Timothy P.; Howden, Benjamin P. (3 de septiembre de 2018). «Global spread of three multidrug-resistant lineages of Staphylococcus epidermidis». Nature Microbiology (en inglés) 3 (10): 1175-1185. PMC 6660648. PMID 30177740. doi:10.1038/s41564-018-0230-7. Consultado el 25 de enero de 2020.
- Reller, Reller y Ryan, 2018, p. 470.
- Otto, M (2009). «Staphylococcus epidermidis — the 'accidental' pathogen.». Nature reviews. Microbiology (en inglés) 7 (8): 555-67. PMC 2807625. PMID 19609257. doi:10.1038/nrmicro2182. Consultado el 19 de enero de 2020.
- «Staphylococcus epidermidis». VetBact (en inglés). Consultado el 17 de enero de 2020.
- «Lab 16 Enzyme-Mediated Biochemical Activities of Bacteria: Physiological Testing II». Universidad de Wyoming (en inglés). Consultado el 23 de abril de 2020.
- Murray, Rosenthal y Pfaller, 2013, pp. 178-179.
- Levinson, 2016, p. 115.
- Antunes, AL; Secchi, C; Reiter, KC; Perez, LR; de Freitas, AL; D'Azevedo, PA (2008). «Feasible identification of Staphylococcus epidermidis using desferrioxamine and fosfomycin disks.». Acta pathologica, microbiologica, et immunologica Scandinavica (en inglés) 116 (1): 16-20. PMID 18254775. doi:10.1111/j.1600-0463.2008.00796.x. Consultado el 25 de enero de 2020.
- Edwards, K. J.; Kaufmann, M. E.; Saunders, N. A. (1 de septiembre de 2001). «Rapid and Accurate Identification of Coagulase-Negative Staphylococci by Real-Time PCR». Journal of Clinical Microbiology (en inglés) 39 (9): 3047-3051. PMC 88294. PMID 11526126. doi:10.1128/jcm.39.9.3047-3051.2001. Consultado el 24 de enero de 2020.
- Martineau, F.; Picard, F. J.; Ke, D.; Paradis, S.; Roy, P. H.; Ouellette, M.; Bergeron, M. G. (1 de julio de 2001). «Development of a PCR Assay for Identification of Staphylococci at Genus and Species Levels». Journal of Clinical Microbiology (en inglés) 39 (7): 2541-2547. PMC 88182. PMID 11427566. doi:10.1128/JCM.39.7.2541-2547.2001. Consultado el 22 de abril de 2020.
- Carpaij, N.; Willems, R. J. L.; Bonten, M. J. M.; Fluit, A. C. (26 de febrero de 2011). «Comparison of the identification of coagulase-negative staphylococci by matrix-assisted laser desorption ionization time-of-flight mass spectrometry and tuf sequencing». European Journal of Clinical Microbiology & Infectious Diseases (en inglés) 30 (10): 1169-1172. PMC 3172412. PMID 21359622. doi:10.1007/s10096-011-1204-3. Consultado el 24 de enero de 2020.
- Licitra, Giancarlo (septiembre de 2013). «Etymologia: Staphylococcus». Emerging Infectious Diseases 19 (9): 1553. PMC 3810938. doi:10.3201/eid1909.ET1909. Consultado el 18 de enero de 2020.
- Ogston, Alexander (1881). «Report upon Micro-Organisms in Surgical Diseases». British Medical Journal 1 (1054): 369-375. PMC 2263466. PMID 20749809. doi:10.1136/bmj.1.1054.369. Consultado el 18 de enero de 2020.
- Murray, Rosenthal y Pfaller, 2013, p. 174.
- Kiers, Paskal J. M.; Bos, Rolf; van der Mei, Henny C.; Busscher, Henk J. (1 de marzo de 2001). «The electrophoretic softness of the surface of Staphylococcus epidermidis cells grown in a liquid medium and on a solid agar». Microbiology (en inglés) 147 (3): 757-762. PMID 11238983. doi:10.1099/00221287-147-3-757. Consultado el 28 de enero de 2020.
- Schleifer, K. H.; Kloos, W. E. (1975). «Isolation and Characterization of Staphylococci from Human Skin I. Amended Descriptions of Staphylococcus epidermidis and Staphylococcus saprophyticus and Descriptions of Three New Species Staphylococcus cohnii, Staphylococcus haemolyticus, and Staphylococcus xylosus». International Journal of Systematic Bacteriology (en inglés) 25 (1): 50-61. ISSN 0020-7713. doi:10.1099/00207713-25-1-50.
- Kaiser, Gary E. «Staphylococcus epidermidis Growing on Mannitol Salt Agar». Community College of Baltimore County (en inglés). Consultado el 23 de abril de 2020.
- Durán Vila, Anabel; Zhurbenko, Raisa; Viera Oramas, Diana R. (2004). «Propuesta de una modificación en la formulación del medio agar manitol salado utilizado en el aislamiento de estafilococos de importancia clínica». Revista Cubana de Medicina Tropical 56 (3): 172-177.
- Murray, Rosenthal y Pfaller, 2013, p. 185.
- Schleifer y Bell, 2015, p. 18.
- Cain, Donna; Hanks, Hershell; Weis, Mary; Bottoms, Carroll; Lawson, Jonathan (2017). Microbiology Laboratory Manual (en inglés). p. 44. Consultado el 7 de mayo de 2020.
- Sánchez-Neira, Yaline; Angarita-Merchán, Maritza (5 de enero de 2018). «Determinación de hemólisis en cepas de Staphylococcus spp causantes de mastitis bovina». Revista Investigación en Salud Universidad de Boyacá 5 (1): 15-30. doi:10.24267/23897325.266. Consultado el 23 de abril de 2020.
- Murray, Rosenthal y Pfaller, 2013, p. 186.
- «Staphylococcus epidermidis (ID 155)». Genome (en inglés). NCBI. Consultado el 18 de enero de 2020.
- Zhang, Yue-Qing; Ren, Shuang-Xi; Li, Hua-Lin; Wang, Yong-Xiang; Fu, Gang; Yang, Jian; Qin, Zhi-Qiang; Miao, You-Gang; Wang, Wen-Yi; Chen, Run-Sheng; Shen, Yan; Chen, Zhu; Yuan, Zheng-Hong; Zhao, Guo-Ping; Qu, Di; Danchin, Antoine; Wen, Yu-Mei (11 de agosto de 2003). «Genome-based analysis of virulence genes in a non-biofilm-forming Staphylococcus epidermidis strain (ATCC 12228)». Molecular Microbiology (en inglés) 49 (6): 1577-1593. PMID 12950922. doi:10.1046/j.1365-2958.2003.03671.x. Consultado el 18 de enero de 2020.
- Gill, SR; Fouts, DE; Archer, GL; Mongodin, EF; Deboy, RT; Ravel, J; Paulsen, IT; Kolonay, JF; Brinkac, L; Beanan, M; Dodson, RJ; Daugherty, SC; Madupu, R; Angiuoli, SV; Durkin, AS; Haft, DH; Vamathevan, J; Khouri, H; Utterback, T; Lee, C; Dimitrov, G; Jiang, L; Qin, H; Weidman, J; Tran, K; Kang, K; Hance, IR; Nelson, KE; Fraser, CM (de abril de 2005). «Insights on evolution of virulence and resistance from the complete genome analysis of an early methicillin-resistant Staphylococcus aureus strain and a biofilm-producing methicillin-resistant Staphylococcus epidermidis strain». Journal of bacteriology (en inglés) 187 (7): 2426-38. PMC 1065214. PMID 15774886. doi:10.1128/JB.187.7.2426-2438.2005. Consultado el 27 de enero de 2020.
- Nguyen, TH; Park, MD; Otto, M (2017). «Host Response to Staphylococcus epidermidis Colonization and Infections.». Frontiers in cellular and infection microbiology (en inglés) 7. PMID 28377905. doi:10.3389/fcimb.2017.00090. Consultado el 18 de enero de 2020.
- Kogan, Grigorij; Sadovskaya, Irina; Chaignon, Philippe; Chokr, Ali; Jabbouri, Saïd (2006). «Biofilms of clinical strains of Staphylococcus that do not contain polysaccharide intercellular adhesin». FEMS Microbiology Letters (en inglés) 255 (1): 11-16. doi:10.1111/j.1574-6968.2005.00043.x.
- Mack, D; Fischer, W; Krokotsch, A; Leopold, K; Hartmann, R; Egge, H; Laufs, R (1996). «The intercellular adhesin involved in biofilm accumulation of Staphylococcus epidermidis is a linear beta-1,6-linked glucosaminoglycan: purification and structural analysis.». Journal of bacteriology (en inglés) 178 (1): 175-183. PMC 177636. PMID 8550413. doi:10.1128/jb.178.1.175-183.1996. Consultado el 19 de enero de 2020.
- Murray, Rosenthal y Pfaller, 2013, pp. 184-185.
- Castro-Delgado, Óscar Eduardo; Salas-Delgado, Íngrid; Acosta-Argoty, Francisco Alfredo; Delgado-Noguera, Mario; Calvache, José Andrés (enero de 2016). «Muy bajo y extremo bajo peso al nacer». Pediatría 49 (1): 23-30. doi:10.1016/j.rcpe.2016.02.002. Consultado el 7 de mayo de 2020.
- Durand, M.L. (marzo de 2013). «Endophthalmitis». Clinical Microbiology and Infection (en inglés) 19 (3): 227-234. PMC 3638360. PMID 23438028. doi:10.1111/1469-0691.12118. Consultado el 7 de mayo de 2020.
- Loza Fernández de Bobadilla, Planes Reig y Rodríguez Creixems, 2003, p. 3.
- Loza Fernández de Bobadilla, Planes Reig y Rodríguez Creixems, 2003, pp. 7-10.
- Murray, Rosenthal y Pfaller, 2013, p. 188.
- De Paulis, A. N.; Predari, S. C.; Chazarreta, C. D.; Santoianni, J. E. (1 de marzo de 2003). «Five-Test Simple Scheme for Species-Level Identification of Clinically Significant Coagulase-Negative Staphylococci». Journal of Clinical Microbiology (en inglés) 41 (3): 1219-1224. PMC 150284. PMID 12624054. doi:10.1128/JCM.41.3.1219-1224.2003. Consultado el 20 de enero de 2020.
- Mermel, Leonard A.; Allon, Michael; Bouza, Emilio; Craven, Donald E.; Flynn, Patricia; O’Grady, Naomi P.; Raad, Issam I.; Rijnders, Bart J. A.; Sherertz, Robert J.; Warren, David K. (2009). «Clinical Practice Guidelines for the Diagnosis and Management of Intravascular Catheter‐Related Infection: 2009 Update by the Infectious Diseases Society of America». Clinical Infectious Diseases (en inglés) 49 (1): 1-45. PMC 4039170. PMID 19489710. doi:10.1086/599376. Consultado el 25 de enero de 2020.
- John, Joseph F.; Davidson, Ross J.; Low, Donald E. «Staphylococcus epidermidis and other Coagulase-Negative Staphylococci». antimicrobe.org (en inglés). Consultado el 25 de enero de 2020.
- Wang, Pin-Jia; Xie, Cheng-Bin; Sun, Feng-Hui; Guo, Li-Juan; Dai, Min; Cheng, Xi; Ma, Yong-Xin (22 de junio de 2016). «Molecular Characteristics of Methicillin-Resistant Staphylococcus epidermidis on the Abdominal Skin of Females before Laparotomy». International Journal of Molecular Sciences (en inglés) 17 (6): 992. PMC 4926520. PMID 27338374. doi:10.3390/ijms17060992. Consultado el 7 de mayo de 2020.
- Singh et al., 2019, pp. 30-31.
- Candel, FJ; Baos, E; Nieto, M; Picazo, JJ (agosto de 2015). «Could ceftaroline be an alternative therapy for linezolid resistant Staphylococcus epidermidis infections in Intensive Care Medicine?». Revista española de quimioterapia: publicación oficial de la Sociedad Española de Quimioterapia (en inglés) 28 (4): 214-6. PMID 26200031. Consultado el 7 de mayo de 2020.
- Krediet, TG; Mascini, EM; van Rooij, E; Vlooswijk, J; Paauw, A; Gerards, LJ; Fleer, A (2004). «Molecular epidemiology of coagulase-negative staphylococci causing sepsis in a neonatal intensive care unit over an 11-year period.». Journal of clinical microbiology (en inglés) 42 (3): 992-5. PMC 356815. PMID 15004043. doi:10.1128/JCM.42.3.992-995.2004. Consultado el 25 de enero de 2020.
- Jones, Ronald N. (1 de enero de 2006). «Microbiological Features of Vancomycin in the 21st Century: Minimum Inhibitory Concentration Creep, Bactericidal/Static Activity, and Applied Breakpoints to Predict Clinical Outcomes or Detect Resistant Strains». Clinical Infectious Diseases (en inglés) 42 (Suplemento 1): S13-S24. PMID 16323115. doi:10.1086/491710. Consultado el 25 de enero de 2020.
Bibliografía
- Levinson, W. (2016). «Gram-Positive Cocci». Review of Medical Microbiology and Immunology (en inglés) (14.ª edición). pp. 109-127. ISBN 978-1-259-25127-6.
- Loza Fernández de Bobadilla, Elena; Planes Reig, Ana; Rodríguez Creixems, Marta (2003). «3a. Hemocultivos». Procedimientos en Microbiología Clínica (2.ª edición). Sociedad Española de Enfermedades Infecciosas y Microbiología Clínica. ISBN 84-609-2289-8. Consultado el 19 de enero de 2020.
- Murray, Patrick L.; Rosenthal, Ken S.; Pfaller, Michael A. (2013). Microbiología médica (7.ª edición). Elsevier. ISBN 978-84-9022-411-3.
- Reller, L. Barth; Reller, Megan E.; Ryan, Kenneth J. (2018). «Infection—Basic Concepts». En Ryan, Kenneth J., ed. Sherris Medical Microbiology (en inglés) (7.ª edición). McGraw-Hill Education. pp. 3-18. ISBN 978-1-25-985981-6.
- Schleifer, Karl-Heinz; Bell, Julia A. (2015). «Staphylococcus». Bergey's Manual of Systematics of Archaea and Bacteria (en inglés). pp. 1-43. ISBN 9781118960608. doi:10.1002/9781118960608.gbm00569. Consultado el 23 de abril de 2020.
- Singh, Khusbu; Mohapatra, Pradumna K.; Pati, Sanghamitra; Dwivedi, Gaurav Raj (2019). «Genetics and Molecular Biology of Genes Encoding Cephalosporin Biosynthesis in Microbes». En Singh, Harikesh Bahadur; Gupta, Vijai Kumar; Jogaiah, Sudisha, eds. Microbial genes biochemistry and applications (en inglés). Elsevier. pp. 25-34. ISBN 978-0-444-63503-7. doi:10.1016/B978-0-444-63503-7.00002-4. Consultado el 7 de mayo de 2020.
Enlaces externos
Wikimedia Commons alberga una categoría multimedia sobre Staphylococcus epidermidis.
Wikispecies tiene un artículo sobre Staphylococcus epidermidis.- Ficha de la cepa tipo de Staphylococcus epidermidis (ATCC 14990) en la base de datos BacDive.

